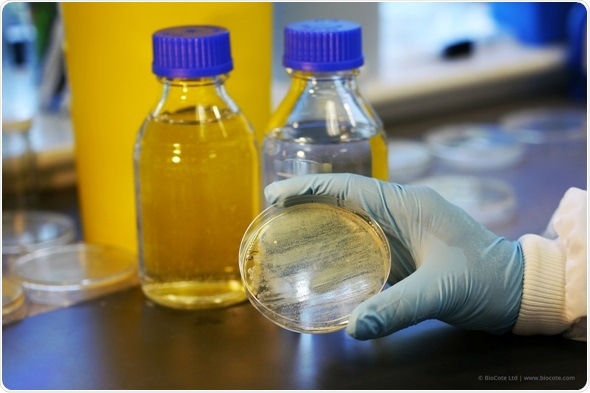

BioCote is proven effective against E.coli and Salmonella, antibiotic resistant superbugs like MRSA, VRE, CPE and CRE, invasive fungi species such as Candida auris, plus H1N1 influenza, H7N9 and the current Aussie/French flu strain.
Exposure to BioCote treated materials (like the surface of the Fortified glove) prevents microbial colonization and also renders them non-infectious, through protein and oxidative damage, membrane disruption and DNA interference.
It’s a consistently reliable and proven complementary strategy for the cross contamination issue prevalent within hospitals, treatment centers, care homes and pharmaceutical facilities. Measures to control the spread of infection in such highly populated settings are widely practiced but currently have limited success.
Ionic silver particles are simply impregnated into the Unigloves synthetic nitrile (prior to vulcanization) during production and homogeneously dispersed throughout the rubber polymer, as opposed to being added as a surface coating which can wear off. Silver is an ideal antimicrobial agent due to its effectiveness against a wide range of microorganisms and this protection lasts the lifetime of the Fortified glove – it will not wear or wash off, or leach out.
Unigloves Fortified gloves meet the medical standard for pinholes (AQL 1.5) and are tested in accordance with EN455 (medical grade). They are latex and powder free, chemical resistant and also available in sizes small to X Large. Visit https://unigloves.co.uk/products/glove-ranges/fortified/
Chris Wahlers, Managing Director of Unigloves, says:
As a renowned solutions provider, we’re confident that Fortified will quickly become a must have for our healthcare and hygiene critical clients. Such premises are a breeding ground because of shared facilities and enclosed spaces, circulated air, common contact surfaces and extended mixing, plus common disinfectants have limited residual effects and bacterial populations are rapidly displaying increased resistance to them.
Going the extra mile and protecting our gloves with a silver ion based BioCote antimicrobial agent will not only significantly reduce the risk of microbial contamination, but considerably improve duty of care to staff and customers. We have rigorously tested product efficacy to ISO 22196:2001, but partnering with BioCote has helped us no end, as they repeatedly test the real-life benefits of protected products by assessing their antimicrobial performance in the toughest environments like hospitals and laboratories.
Guy Charteris, Partner Development Manager for BioCote, adds:
Our quality control procedures really are second to none – products are subjected to 25-year accelerated life cycle testing - and require Unigloves to consistently demonstrate above our own global standards of antimicrobial performance to continue carrying our trademark. No other antimicrobial provider enforces this measure, but to their credit they welcome this level and degree of transparency too.
What a forward thinking and innovative partner like Unigloves also gets from BioCote is a complete support package – this covers all things antimicrobial, not to mention data to support any marketing claims (a legal requirement), plus of course peace of mind their product and ours is doing exactly what we say it is.